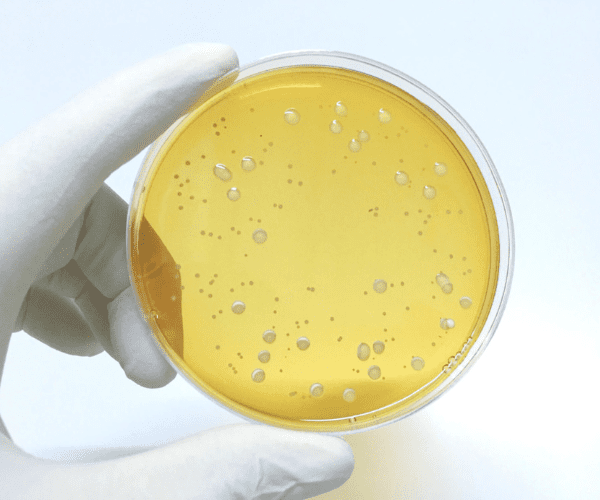
Bioburden Reduction Packing Material

In modern manufacturing, the sterilization or bioburden reduction of packaging materials plays a crucial role. It not only supports consistent production outcomes but also safeguards the quality and safety of the end products. With the growing demand for cosmetic and food products that are free from preservatives, effective sterilization methods have become more important than ever. By ensuring that packaging itself is free from harmful microorganisms, manufacturers make a direct contribution to protecting consumers and meet rising expectations for safe, high-quality goods.
Why Sterilizing Packaging Matters
Sterile primary packaging for the pharmaceutical, medical, biotech and food industries is a critical component of the supply chain. Radiation treatment of packaging before filling prevents products from:
- Formulation damage – Keeps sensitive products intact.
- Microbial contamination – Blocks bacteria, viruses, and fungi.
- Quality loss – Preserves product degradation over time.
- Health risks – Ensures patient and end-user safety
Applications Across the Industries
E-Beam Sterilization is widely used across different industries to ensure that packaging materials are free from harmful microorganisms before they come into contact with sensitive products. In the pharmaceutical sector, this includes:
- Ampoules
- Bottles
- Cans
- Tubes and pouches
—materials that directly interact with medicines (e.g., syrups or injectable solutions) must therefore meet strict legal and regulatory requirements.
In the food industry, applications range from bag-in-box systems, liners, flextanks, outlet valves, plastic capsules, and various closures (inserts, caps, plugs, rings, etc). Sterilizing these materials not only supports compliance with regulations but also extends shelf life, protects product integrity, and reduces risks for consumers.
Beyond pharmaceutical and food packaging, BGS US mainly supports manufacturers in sterilizing a wide range of specialized packaging and products, including:
- Medical device packaging – syringe blister packs, sterile trays, and pouches.
- Single-use bioprocessing equipment – bags, tubing, fittings, and manifolds.
- Laboratory consumables – pipette tip boxes, petri dish sleeves, and reagent bottles.
- Finished products – medical devices, pharmaceuticals, and lab consumables.


How E-Beam Sterilization Works
High-energy electrons disrupt the DNA or RNA of microorganisms, instantly stopping their ability to reproduce. Processing is completed in seconds to minutes. Benefits include:
- Immediate usability – After irradiation, the products are immediately usable, eliminating the need for costly storage.
- Controlled penetration – Thanks to its low penetration depth and high dosage rates, the process is particularly suitable for sensitive products with low to medium density.
- Environmentally friendly and safe – E-Beam is considered an efficient and sustainable solution for sterilization. Due to physical properties, the radiation used at BGS US does not generate any radioactivity. The treated products are free of any harmful residues for humans and the environment.

Compared to gamma or ethylene oxide (EtO), E-Beam offers unmatched speed, environmental advantages, and supply chain flexibility.
Why Manufacturers Choose BGS US
BGS US, with a 100,000 square-foot facility near major highways and the Pittsburgh International Airport, specializes in high-precision E-Beam radiation sterilization. By integrating sterilization as a controlled step in production, we help manufacturers maintain product quality, extend shelf life, and protect end users.
Sterilization involves more than delivery and return; it requires planning, validation, and quality control. BGS US stands out with:
- Proven expertise – 40+ years of global radiation sterilization experience.
- Highly Automated systems – Conveyor handling reduces human error and ensures high speed.
- Fast turnaround – Most orders processed and returned in 5–10 business days.
- Regulatory compliance – ISO 11137, ISO 9001, ISO 13485 certified.
- Strategic logistics – Conveniently located for efficient shipping.

Integrated Into Your Workflow
Sterilization at BGS US is a managed production step, not just an outsourced service. Every order is tracked from receipt to delivery for full traceability and consistent, repeatable results. Products are ready for immediate use, filling, or distribution.
Protect Your Products, and Patients
For manufacturers that demand sterility, compliance, and quick turnaround, BGS US offers fast, precise, and environmentally responsible E-Beam sterilization. Decades of expertise and a state-of-the-art U.S. facility make partnering with BGS US a smart choice for protecting product integrity and streamlining production. See how our E-Beam sterilization services can safeguard your products, improve efficiency, and protect end users.
